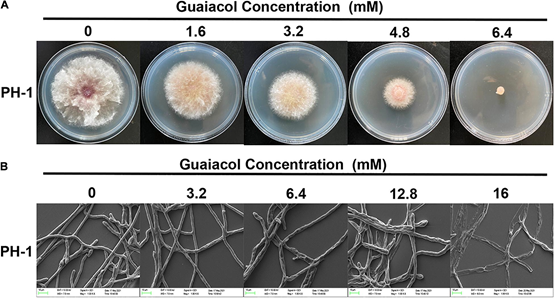
香精與香料(70)—愈創(chuàng)木酚 香精與香料(70)—愈創(chuàng)木酚

服務(wù)熱線
177-5061-9273

愈創(chuàng)木酚(guaiacol)(或作愈創(chuàng)木酚,得名于原產(chǎn)自拉丁美洲的愈創(chuàng)樹)是一種天然有機(jī)物,分子式為 C6H4(OH)(OCH3)。這種無(wú)色芳香油狀化合物是木餾油的主要成分,可從愈創(chuàng)木樹脂、松油等制取。常見的愈創(chuàng)木酚因暴露在空氣中或光照下而呈現(xiàn)深色。由于木質(zhì)素的分解,木柴燃燒時(shí)產(chǎn)生的煙霧中含有愈創(chuàng)木酚。許多食物因含有愈創(chuàng)木酚而具有特殊氣味,例如烘焙咖啡豆。熏制食物的特殊風(fēng)味主要屬愈創(chuàng)木酚與丁香酚的作用。愈創(chuàng)木酚遇三氯化鐵變?yōu)樗{(lán)色。GB 2760—96規(guī)定為暫時(shí)允許使用的食用香料。主要用于配制咖啡、香草、熏煙和煙草等型香精。

愈創(chuàng)木酚
IUPAC名:2-甲氧基苯酚
別名:鄰甲氧基苯酚;鄰苯二酚甲醚
化學(xué)性質(zhì):白色或微黃色結(jié)晶或無(wú)色至淡黃色透明油狀液體。有特殊芳香氣味。略溶于水和苯。易溶于甘油。與乙醇、乙醚、氯仿、油類、冰醋酸混溶。嗅覺閾值(Odor Threshold): 0.0074ppm。
| 識(shí)別 | |
| CAS號(hào) | 90-05-1 |
| FEMA | 2532 |
| PubChem | 460 |
| ChemSpider | 447 |
| 性質(zhì) | |
| 化學(xué)式 | C7H8O2 |
| 摩爾質(zhì)量 | 124.14克/摩爾 g·mol?1 |
| 密度 | 液態(tài)1.112 g/cm3 固態(tài)1.129 g/cm3 |
| 熔點(diǎn) | 28 °C(301 K) |
| 沸點(diǎn) | 204-206 °C |
| 若非注明,所有數(shù)據(jù)均出自一般條件(25 ℃,100 kPa)下。 | |
制備
在自然界中愈創(chuàng)木酚存在于愈創(chuàng)樹脂或松油中,在木材干餾所得的雜酚油中,愈創(chuàng)木酚是主要的成分,將雜酚油分餾可得該品。日本大阪精化公司以鄰硝基氯苯為原料,制成鄰硝基苯甲醚,進(jìn)而還原為鄰氨基苯甲醚,最后制得該品。我國(guó)生產(chǎn)方法與此大致相同。原料消耗定額:含氨基苯甲醚1250kg/t、硫酸(93%)1500kg/t、亞硝酸鈉700kg/t、硫酸銅400kg/t。工業(yè)上常通過(guò)對(duì)鄰苯二酚甲基化生產(chǎn)愈創(chuàng)木酚。例如用碳酸鉀與硫酸二甲酯和鄰苯二酚反應(yīng):
C6H4(OH)2+ (CH3O)2SO2 → C6H4(OH)(OCH3) + HO(CH3O)SO2
愈創(chuàng)木酚也可以通過(guò)干餾木材制得的木餾油得到其混合物。
實(shí)驗(yàn)室制備
愈創(chuàng)木酚有多種實(shí)驗(yàn)室制法。例如可以以鄰硝基氯苯為原料,通過(guò)威廉姆遜合成法合成鄰硝基苯甲醚,再還原硝基為氨基,最后通過(guò)重氮化水解反應(yīng)合成最終目標(biāo)產(chǎn)物。中國(guó)與日本企業(yè)也常用此途徑工業(yè)生產(chǎn)愈創(chuàng)木酚。另一種合成愈創(chuàng)木酚的方法是鄰苯二酚甲基化后再選擇性部分水解:
C6H4(OCH3)2+ C2H5SNa → C6H4(OCH3)(ONa) + C2H5SCH3
毒性
LD50 900 mg/kg(大鼠,皮下)。LD50 3.7mg/kg(家兔,靜注)。大量口服可刺激食道和胃部,以致心肌衰竭、虛脫而致死。
使用限量
FEMA(mg/kg):軟飲料0.95;冷飲0.52;糖果0.96;焙烤食品0.75。適度為限(FDA§172.515,2000)。
用途
愈創(chuàng)木酚在工業(yè)上用途廣泛。常用愈創(chuàng)木酚來(lái)生產(chǎn)各種香料,如丁香油酚、香蘭素和人造麝香。愈創(chuàng)木酚在醫(yī)藥上也有大量應(yīng)用,它可被用于合成苯磺酸愈創(chuàng)木酚(愈創(chuàng)木酚磺酸鉀)、用作局部麻醉劑或防腐劑,還可以祛痰和治療消化不良。因?yàn)榫哂羞€原性,常在化妝品中少量添加作為抗氧化劑并常與增效劑、金屬離子螯合劑等一同使用。因?yàn)榕c氧反應(yīng)會(huì)顯深色,愈創(chuàng)木酚還被用作染料。愈創(chuàng)木酚也用作有機(jī)合成原料及分析測(cè)定的標(biāo)準(zhǔn)物質(zhì)。
相關(guān)化合物
愈創(chuàng)木酚與甘油形成的醚(愈創(chuàng)甘油醚)是常用祛痰藥,又稱格力特或去咳露。愈創(chuàng)木酚的另一種衍生物鄰苯二甲醚(又稱白藜蘆素或藜蘆醚)也是常用化工產(chǎn)品。
安全性
愈創(chuàng)木酚可被用作吸入煙霧的指示物,因?yàn)閺氖澄镏袛z取的愈創(chuàng)木酚量遠(yuǎn)多于通過(guò)呼吸吸入的煙氣中的愈創(chuàng)木酚含量。
愈創(chuàng)木酚的生物合成
1、 結(jié)合轉(zhuǎn)錄組和蛋白質(zhì)組分析探討酸地脂環(huán)芽孢桿菌產(chǎn)愈創(chuàng)木酚的機(jī)制
脂環(huán)芽孢桿菌(Alicyclobacillus spp.)可導(dǎo)致商業(yè)巴氏滅菌的果汁/飲料變質(zhì),變質(zhì)的特征是形成一種獨(dú)特的藥用或防腐劑的異味,歸因于愈創(chuàng)木酚。本研究旨在結(jié)合轉(zhuǎn)錄組學(xué)和蛋白質(zhì)組學(xué)方法,揭示酸土脂環(huán)酸芽孢桿菌(Alicyclobacillus acidoterrestris)產(chǎn)生愈創(chuàng)木酚的機(jī)制。通過(guò)RNA測(cè)序和iTRAQ分析,研究了產(chǎn)(含500 μM香草酸)和不產(chǎn)(不含香草酸)愈創(chuàng)木酚時(shí),酸土脂環(huán)酸芽孢桿菌基因和蛋白表達(dá)水平的差異。共鑒定出225個(gè)差異表達(dá)基因和77個(gè)差異表達(dá)蛋白。編碼香草酸脫羧酶亞基的基因vdcBCD的轉(zhuǎn)錄分別上調(diào)了626.47、185.01和52.81倍;它們是愈創(chuàng)木酚生產(chǎn)中上調(diào)最多的基因。苯甲酸膜轉(zhuǎn)運(yùn)蛋白、鐮刀酸抗性蛋白、抗性-結(jié)節(jié)-分裂轉(zhuǎn)運(yùn)蛋白、一些ATP結(jié)合盒轉(zhuǎn)運(yùn)蛋白和主要促進(jìn)因子超家族轉(zhuǎn)運(yùn)蛋白在mRNA、蛋白或兩個(gè)水平上的表達(dá)均增加。說(shuō)明它們參與了香草酸的吸收和愈創(chuàng)木酚的合成。在酸土脂環(huán)酸芽孢桿菌利用香草酸合成愈創(chuàng)木酚的代謝過(guò)程中,三羧酸循環(huán)途徑和核糖體相關(guān)基因表達(dá)上調(diào),而纈氨酸、亮氨酸和異亮氨酸生物合成相關(guān)基因表達(dá)降低。這些發(fā)現(xiàn)為了解愈創(chuàng)木酚的產(chǎn)生機(jī)制提供了新的思路,為果汁工業(yè)中愈創(chuàng)木酚的防治提供了重要的指導(dǎo)。

圖1 愈創(chuàng)木酚的生物合成示意圖 [1]
愈創(chuàng)木酚在香精行業(yè)中的應(yīng)用
天然香草香精的鑒定:將香草醛降解成愈創(chuàng)木酚的同位素表征 [2]
本文將香蘭素的同位素研究擴(kuò)展到近年來(lái)發(fā)現(xiàn)的香蘭素天然前體的新來(lái)源,以期通過(guò)生物技術(shù)方法獲得天然香蘭素。為了檢驗(yàn)香草醛的同位素組成與相應(yīng)芳香族片段的一致性,進(jìn)行了愈創(chuàng)木酚選擇性降解反應(yīng)。實(shí)驗(yàn)表明,該反應(yīng)可以在沒(méi)有顯著的同位素分餾的情況下進(jìn)行,并從實(shí)驗(yàn)設(shè)計(jì)的結(jié)果中確定了一個(gè)優(yōu)化的過(guò)程,該實(shí)驗(yàn)設(shè)計(jì)包括了試劑的數(shù)量、溫度和實(shí)驗(yàn)時(shí)間。愈創(chuàng)木酚是碳氧同位素比值質(zhì)譜(IRMS)測(cè)定的一種有趣的同位素探針。它提供了芳香片段特定的(13)C信息,并結(jié)合香蘭素本身測(cè)量的(13)C值,提高了碳- IRMS的鑒定潛力。因此,阿魏酸的自然狀態(tài)可以通過(guò)在甲酰位點(diǎn)大量消耗C來(lái)表征。同樣,愈創(chuàng)木酚的氧-18含量是比香蘭素的δ (18)O更好的鑒定工具,因?yàn)樵诠I(yè)或?qū)嶒?yàn)室程序中,它不受sp(2)氧原子與水的化學(xué)交換所改變的缺點(diǎn)。盡管協(xié)作研究仍是必要的,以提高delta(18)O參數(shù)的實(shí)驗(yàn)室間重現(xiàn)性,但在實(shí)驗(yàn)室內(nèi)部可以獲得一致的結(jié)果。特別表明,阿魏酸的化學(xué)氧化特征是香蘭素的芳香部分的相對(duì)富集。

圖2 香蘭素的三大來(lái)源

圖3 香蘭素前體分子結(jié)構(gòu):1a, R) CH3(異丁香酚);1b, R) COOH(阿魏酸);1c, R) COCH2R '(姜黃素)。1a?c如圖4所示。
人們對(duì)香草的鑒定進(jìn)行了大量研究,認(rèn)為從香草豆中提取的天然產(chǎn)品比其合成或半合成的同類產(chǎn)品價(jià)值高得多。穩(wěn)定同位素分析,通過(guò)同位素比質(zhì)譜(IRMS)和核磁共振(SNF- NMR)進(jìn)行,為區(qū)分香莢蘭豆和其他兩個(gè)重要來(lái)源愈愈木酚和木質(zhì)素提供了非常強(qiáng)大的工具(圖2)。對(duì)香草口味的需求增加,香莢蘭豆天然提取物的供應(yīng)相對(duì)短缺,這催生了市場(chǎng)上主要調(diào)味成分香草醛的新來(lái)源的開發(fā)。這些來(lái)源主要是依然來(lái)自于天然產(chǎn)物的前體,其分子結(jié)構(gòu)如圖3中所述,R) - CH3(異丁子香酚,1a,從丁香酚的丁香油),R)羧基(阿魏酸,1 b,從米糠或甜菜漿),或R) CO-CH2-R”(姜黃素,1 c,從姜科的根)。從這些分子中得到的香蘭素涉及到側(cè)雙鍵的氧化裂解(圖4)。

圖4 從阿魏酸、姜黃素或異丁香酚中提取的香草醛的新來(lái)源。

圖5 香草醛降解為愈創(chuàng)木酚的反應(yīng)式
因此,身份驗(yàn)證問(wèn)題是雙重的。首先,前體的天然狀態(tài)需要驗(yàn)證,其次,將前體轉(zhuǎn)化為香草醛的過(guò)程必須保證不經(jīng)過(guò)任何化學(xué)步驟。之前的研究已經(jīng)確定了甲酰基或甲氧基是否因非法操作香草醛分子而發(fā)生了任何不尋常的13C或2H富集。最近,香蘭素的氧同位素比值δ18O也被提出作為區(qū)分天然樣品與愈創(chuàng)木酚和木質(zhì)素來(lái)源的有效附加參數(shù)。然而,在任何制備和純化步驟中,香蘭素甲酰基的氧原子很容易與水發(fā)生化學(xué)交換。因此,有必要開發(fā)一種新的工具來(lái)克服18O程序的這一缺點(diǎn),并將香草醛降解成愈創(chuàng)木酚被認(rèn)為是擺脫了這一缺點(diǎn)??紤]到鑒定標(biāo)準(zhǔn)的需要,包括香草醛的新生物技術(shù)來(lái)源,這項(xiàng)工作的目的還在于根據(jù)碳和氧同位素?cái)?shù)據(jù)確定不同前體香草醛樣品的置信域,并研究氧化裂解對(duì)所得分子的同位素參數(shù)的影響。(香草醛轉(zhuǎn)化成愈創(chuàng)木酚的研究。該反應(yīng)涉及到苯-甲酰鍵與鈀的催化裂解(圖4)。在一個(gè)裝有冷凝器的250ml圓底燒瓶中,注入等量的香草醛(至少200mg)和1% w/w的沉積在活性炭上的鈀。手動(dòng)攪拌混合物,在210℃的油浴中回流2小時(shí)。然后將混合物冷卻到室溫30分鐘,所得愈創(chuàng)木酚溶解在30-40毫升二氯甲烷中。然后在真空條件下,通過(guò)熔塊玻璃漏斗(No. 4.))
碳同位素比值。對(duì)于來(lái)自天然前體(豆類、阿魏酸、木質(zhì)素和異丁香酚)的香草醛,愈創(chuàng)木酚分子在13C中略有富集(樣本1b除外)。計(jì)算的平均值為1.3‰。相比之下,化石前體則略有減少(≈-1‰)。這種行為表明,在合成產(chǎn)物中,相對(duì)于來(lái)自天然來(lái)源的相同片段,香草醛的甲酰基在13C中富集。這一觀察結(jié)果與氫同位素參數(shù)的典型行為相一致,與用于合成香草醛的乙醛酸的高13C含量(~ -20‰)相一致。與Krueger和Nicol的結(jié)果一致。盡管公式1計(jì)算的δ13C(CHO)值精度有限,但可以得出結(jié)論,香草醛從非天然阿魏酸中損失的甲?;貏e高(樣品4和6a-c的δ13C值在-38‰和-67‰之間)。這些結(jié)果有力地支持了從天然阿魏酸中提取香草醛的δ13C值(平均δ13C值為-36.9‰,樣品4和樣品6a-c)來(lái)確定其天然狀態(tài)。此外,香蘭素前體天然阿魏酸(δ13C) -34.4‰樣品4和6a-c)與米糠阿魏酸(δ13C) -35.5‰樣品的平均13C含量相似。
氧同位素比率。在實(shí)踐中,氧同位素比率在認(rèn)證程序中并不起重要作用。如前一節(jié)所討論的,實(shí)驗(yàn)室間重復(fù)性的低水平使絕對(duì)值的比較變得復(fù)雜,結(jié)果通常必須在相對(duì)的基礎(chǔ)上解釋。此外,必須考慮到由于氧交換而喪失選擇性的風(fēng)險(xiǎn)。因此,在香草醛的情況下,sp2氧原子很可能在樣品的提取和制備過(guò)程中與水發(fā)生交換,香草醛本身并不是一種方便的18O-IRMS通用探針。原則上,從香草醛中提取的愈創(chuàng)木酚較好地避免了交換的風(fēng)險(xiǎn)。此外,其δ18O值僅為兩個(gè)位置以上的平均值,表現(xiàn)出較高的選擇性。還可以確定更多的選擇性參數(shù),但代價(jià)是要進(jìn)一步降解香草醛反應(yīng)。Fronza等人最近發(fā)表了三種前體的選擇性δ18O值:香莢蘭豆、木質(zhì)素和愈創(chuàng)木酚。結(jié)果表明,氧同位素分析提供了有關(guān)這三個(gè)氧原子起源的有趣的機(jī)制信息。從表3的結(jié)果可以評(píng)估愈創(chuàng)木酚作為18O-IRMS探針在合理時(shí)間內(nèi)表征整個(gè)天然、化學(xué)和生物技術(shù)來(lái)源的鑒定潛力。結(jié)果表明,直接測(cè)定的合成和半合成香草醛的18O含量(δ18O)為8.9‰,樣品2a、b和3a-c),而從大豆中提取或從天然前體中提取的香草醛(δ18O)為14.1‰,樣品1a、b、4、6a c和7a、b)。這種差異可能與前體的特定性質(zhì)無(wú)關(guān),而是與提取過(guò)程的工業(yè)或?qū)嶒?yàn)室性質(zhì)有關(guān),因?yàn)闃悠?和3是商業(yè)工業(yè)產(chǎn)品,而其他樣品是在實(shí)驗(yàn)室規(guī)模上制備和提取的。在嚴(yán)格標(biāo)準(zhǔn)化條件下獲得的愈創(chuàng)木酚有望提供一個(gè)氧同位素探針,代表唯一的非交換性原子,因此,較少依賴于樣品處理。雖然δ18O的變化范圍相當(dāng)有限,但可以得出結(jié)論,阿魏酸雙鍵的化學(xué)氧化使香草醛的δ18O值比水溶液中酶的反應(yīng)略有增加。
考慮到香草醛的經(jīng)濟(jì)重要性和引進(jìn)新的生物技術(shù)來(lái)源,人們對(duì)發(fā)展鑒定標(biāo)準(zhǔn)繼續(xù)有興趣。當(dāng)提取的樣品數(shù)量足夠多時(shí),SNIF-NMR方法對(duì)于區(qū)分香草醛的主要來(lái)源特別有效。然而,面對(duì)日益復(fù)雜的欺詐行為和對(duì)稀釋介質(zhì)進(jìn)行調(diào)查的需要,也可以利用內(nèi)部質(zhì)譜儀測(cè)定碳和氧同位素比率。本研究結(jié)果擴(kuò)展了之前的研究,表明以香草醛為原料制備愈創(chuàng)木酚,在可重復(fù)同位素條件下,為測(cè)定碳氧同位素比值提供了一種新的探針,不受甲酰氧交換的干擾。當(dāng)愈創(chuàng)木酚的結(jié)果與測(cè)定香草醛的同位素比率相結(jié)合時(shí),也可以獲得甲?;耐凰睾啃畔?。結(jié)果表明,所建立的將香蘭素降解成愈創(chuàng)木酚的實(shí)驗(yàn)方法是可靠、準(zhǔn)確的。結(jié)果表明,愈創(chuàng)木酚的δ13C值與香草醛的δ13C值的均方差(MSD)為1.77,說(shuō)明愈創(chuàng)木酚是鑒定香草醛前體的一個(gè)很好的補(bǔ)充指標(biāo)。
愈創(chuàng)木酚的藥理活性
1、 抗氧化劑愈創(chuàng)木酚對(duì)禾谷鐮刀菌(Fusarium graminearum)生長(zhǎng)及脫氧雪腐鐮刀菌烯醇的產(chǎn)生具有殺菌和抑制作用
從干木材蒸餾得到的雜酚油的主要成分愈創(chuàng)木酚是一種天然抗氧化劑,廣泛應(yīng)用于醫(yī)藥和食品保鮮。然而愈創(chuàng)木酚的抗真菌機(jī)制尚不清楚。本研究發(fā)現(xiàn)愈創(chuàng)木酚對(duì)禾谷鐮刀菌的菌絲生長(zhǎng)、分生孢子的形成和萌發(fā)以及脫氧雪腐鐮刀菌烯醇(DON)的生物合成具有一定的抑制作用,且呈劑量依賴關(guān)系。愈創(chuàng)木酚對(duì)標(biāo)準(zhǔn)菌株P(guān)H-1的中位有效濃度(EC50)值為1.838 mM。愈創(chuàng)木酚對(duì)孢子的產(chǎn)生和萌發(fā)有較強(qiáng)的抑制作用。愈創(chuàng)木酚的抗真菌作用可能與其破壞Ca2+轉(zhuǎn)運(yùn)通道的能力有關(guān)。此外,愈創(chuàng)木酚處理降低了丙二醛(MDA)水平,降低了過(guò)氧化氫酶(CAT)、過(guò)氧化物酶(POD)和超氧化物歧化酶(SOD)活性,表明愈創(chuàng)木酚通過(guò)調(diào)節(jié)氧化反應(yīng)來(lái)抑制真菌毒素脫氧雪腐鐮刀菌烯醇(Deoxynivalenol, DON)的產(chǎn)生。綜上所述,本研究揭示了抗氧化劑在抑制禾谷鐮刀菌中真菌毒素的潛力。
圖6 愈創(chuàng)木酚抑制禾谷鐮刀菌菌絲生長(zhǎng)。(A)菌株P(guān)H-1在含愈創(chuàng)木酚(0-6.4 mM)的PDA平板上培養(yǎng)3 d,拍照并測(cè)量菌落直徑;(B)愈創(chuàng)木酚(0-16 mM)處理下禾谷鐮刀菌(禾谷鐮刀菌, PH-1)菌絲形態(tài)的SEM觀察[3]
不同濃度愈創(chuàng)木酚處理禾谷鐮刀菌PH-1,愈創(chuàng)木酚對(duì)菌絲生長(zhǎng)的抑制呈劑量依賴性,6.4 mM愈創(chuàng)木酚完全抑制菌絲生長(zhǎng)(圖6A)。愈創(chuàng)木酚對(duì)PH-1的EC50值為1.838 mM。此外,掃描電鏡(SEM)檢測(cè)了愈創(chuàng)木酚對(duì)禾谷鐮刀菌菌絲生長(zhǎng)的影響,可以清楚地看出愈創(chuàng)木酚處理后菌絲形態(tài)發(fā)生了變化。與常規(guī)光滑的對(duì)照組菌絲不同,用16mM愈創(chuàng)木酚處理后菌絲明顯崩壞(圖6B)。
2、 漆酶催化合成愈創(chuàng)木酚寡聚物抗菌粉的研究
以漆酶為催化劑,采用酶催化聚合法制備愈創(chuàng)木酚低聚物。在水溶液中進(jìn)行了紫外-可見光譜反應(yīng)。用核磁共振和MALDI-TOF譜對(duì)其進(jìn)行了表征。紫外-可見光譜觀察顯示,在380 ~ 530 nm范圍內(nèi)形成了一個(gè)新的峰,表明新物質(zhì)的形成。核磁共振結(jié)果表明,酚羥基參與了聚合反應(yīng)。MALDI-TOF譜顯示愈創(chuàng)木酚寡聚物的質(zhì)量平均聚合度為10,重復(fù)單元的質(zhì)量為122。采用熱重分析(TGA/DSC)對(duì)其熱穩(wěn)定性進(jìn)行了研究。愈創(chuàng)木酚低聚物的熱穩(wěn)定性優(yōu)于愈創(chuàng)木酚,這可能與愈創(chuàng)木酚具有較長(zhǎng)的共軛π鏈有關(guān)。ABTS自由基 dot+自由基的抗氧化活性呈濃度依賴性,在800 μg/mL時(shí)達(dá)到平臺(tái)。所得愈創(chuàng)木酚寡聚物對(duì)金黃色葡萄球菌和大腸桿菌均有一定的抑菌活性,抑菌率達(dá)99%。

圖7 愈創(chuàng)木酚寡聚物合成的示意圖 [4]
3、 愈創(chuàng)木酚通過(guò)阻斷RANK與TRAF6和C-Src的相互作用以及抑制NF-κB、MAPK和AKT信號(hào)通路來(lái)抑制破骨細(xì)胞的形成
當(dāng)歸(Angelica sinensis)是一種傳統(tǒng)的中藥,幾百年來(lái)一直被用于治療骨質(zhì)疏松和骨壞死等骨病。但其有效成分和作用機(jī)制尚不清楚。通過(guò)二維細(xì)胞膜色譜/C18柱/飛行時(shí)間質(zhì)譜(2D CMC/C18柱/TOFMS)鑒定愈創(chuàng)木酚為當(dāng)歸的有效成分。愈創(chuàng)木酚在體外抑制骨髓單核細(xì)胞(BMMCs)和RAW264.7細(xì)胞的破骨細(xì)胞生成和破骨細(xì)胞功能,且呈劑量依賴性。免疫共沉淀提示愈創(chuàng)木酚阻斷了RANK-TRAF6和RANK-C-Src的關(guān)聯(lián)。愈創(chuàng)木酚可抑制p65、p50、IκB (NF-κB通路)、ERK、JNK、c-fos、p38 (MAPK通路)和Akt (Akt通路)的磷酸化,降低Cathepsin K、CTR、MMP-9和TRAP的表達(dá)水平。愈創(chuàng)木酚還抑制活化t細(xì)胞胞漿核因子1(NFATc1)的表達(dá)和rankl誘導(dǎo)的Ca2+變化。在體內(nèi),它通過(guò)抑制過(guò)度的破骨細(xì)胞生成來(lái)改善卵巢切除引起的骨丟失。綜上所示,愈創(chuàng)木酚通過(guò)阻斷RANK與TRAF6和C-Src的相互作用,以及抑制NF-κB、MAPK和AKT信號(hào)通路,從而抑制rankl誘導(dǎo)的破骨細(xì)胞形成。因此,該化合物顯示出治療破骨細(xì)胞發(fā)生相關(guān)骨疾病的潛力,包括絕經(jīng)后骨質(zhì)疏松癥。

圖8 愈創(chuàng)木酚提取自AS。A、2D CMC/C18色譜柱/TOFMS系統(tǒng)。B,愈創(chuàng)木酚典型2D色譜儀。C、愈創(chuàng)木酚分子式 [5]
通過(guò)2D BMMC/CMC/C18柱/TOFMS分析,鑒定愈創(chuàng)木酚為as的活性成分,發(fā)現(xiàn)愈創(chuàng)木酚具有明顯的體外破骨細(xì)胞功能和破骨細(xì)胞生成抑制作用。通過(guò)阻斷RANKL/ m - csf和C-Src之間的相互作用,在早期降低RANKL/ m - csf誘導(dǎo)的NF-κB、MAPK和AKT信號(hào)通路的激活。在體內(nèi),它顯著減弱了ovx誘導(dǎo)的骨丟失(圖9)。

圖9 愈創(chuàng)木酚通過(guò)多種信號(hào)通路抑制破骨細(xì)胞分化和功能的機(jī)制 [5]
4、 酮洛芬與天然抗氧化劑(百里酚、薄荷醇和愈創(chuàng)木酚)可能互為前藥的新衍生物的設(shè)計(jì)與合成
非甾體抗炎藥(NSAIDs)是使用最廣泛的一類藥物。它們主要用于治療骨關(guān)節(jié)炎、類風(fēng)濕關(guān)節(jié)炎和其他炎性疾病。然而,非甾體抗炎藥的使用是有限的,因?yàn)榭赡苷T發(fā)胃腸道糜爛和潰瘍。近年來(lái),在非甾體抗炎藥治療相關(guān)的胃潰瘍形成過(guò)程中,局部活性氧(ROS)的產(chǎn)生起著重要作用。因此,在本研究中,非甾體抗炎藥(酮洛芬)已與具有抗?jié)兓钚缘牟煌寡趸瘎?百里酚、薄荷醇和愈創(chuàng)木酚)結(jié)合。目的是獲得Ketoprfen -抗氧化衍生物的相互前藥,包括:酮洛芬-百里酚(化合物I)、酮洛芬-薄荷醇(化合物II)和酮洛芬愈創(chuàng)木酚(化合物III)。非甾體抗炎藥與抗氧化劑的相互前藥被指定為作為單一化學(xué)實(shí)體產(chǎn)生互補(bǔ)藥理作用,改善抗炎作用,減少潰瘍的不良反應(yīng)。通過(guò)FT-IR、CHNS和理化性質(zhì)確定了合成方法。[6]
參考文獻(xiàn)
[1] ZhouliWang, Yunhao Liang, Qi Wang, Hang Jia, Tianli Yue, Yahong Yuan, Zhenpeng Gao,Rui Cai,Integrated analysis of transcriptome and proteome for exploring themechanism of guaiacol production by Alicyclobacillus acidoterrestris, FoodResearch International, 2021,148,110621,doi.10.1016/j.foodres.2021.110621.
[2] Bensaid,Fatiha & Wietzerbin, Karine & Martin, Gérard. (2002). Authentication ofNatural Vanilla Flavorings: Isotopic Characterization Using Degradation ofVanillin into Guaiacol. Journal of agricultural and food chemistry. 50. 6271-5.10.1021/jf020316l.
[3] GaoTao, Zhang Yao, Shi Jianrong, Mohamed Sherif Ramzy, Xu Jianhong, Liu Xin. The Antioxidant Guaiacol Exerts FungicidalActivity Against Fungal Growth and Deoxynivalenol Production in Fusariumgraminearum. Frontiers in Microbiology,2021, 12, DOI.10.3389/fmicb.2021.762844
[4] NannanLi, Jing Su, Hongbo Wang, Artur Cavaco-Paulo, Production of antimicrobialpowders of guaiacol oligomers by a laccase-catalyzed synthesis reaction,Process Biochemistry,2021,111, Part 1, 213-220,doi.10.1016/j.procbio.2021.07.018.
[5] XinZhi,Chao Fang,Yanqiu Gu,Huiwen Chen,Xiaofei Chen,Jin Cui,Yan Hu,WeizongWeng,Qirong Zhou,Yajun Wang,Yao Wang,Hao Jiang,Xiaoqun Li,Liehu Cao,XiaoChen,Jiacan Su. Guaiacol suppresses osteoclastogenesis by blocking interactionsof RANK with TRAF6 and C-Src and inhibiting NF-κB, MAPK and AKT pathways.Journal of Cellular and Molecular Medicine, 2020, 24(9): 5122-5134.
[6]Shaheed, D.Q., Kareem, A., Mubarak,H., Abdul, A., Abbas, H.K., & Dakhil, M.A. (2015). DESIGN AND SYNTHESIS OFNEW DERIVATIVES OF KETOPROFEN LINKED TO NATURAL ANTIOXIDANTS (THYMOL, MENTHOL& GUAIACOL) AS POSSIBLE MUTUAL PRODRUGS.